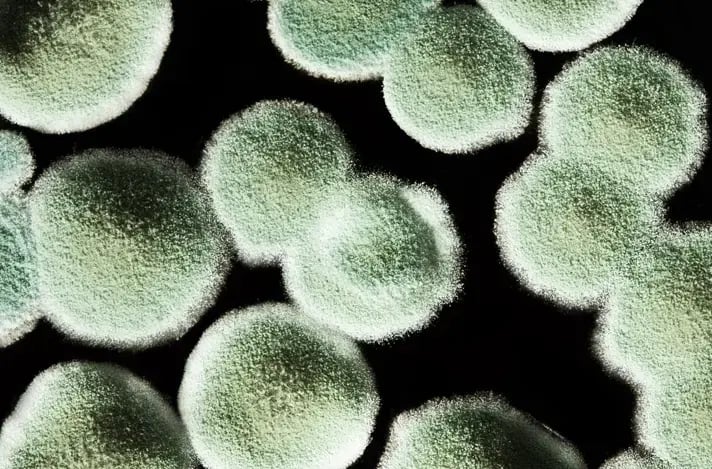
Macro photography of grayish green mold spores.

Smoking moldy flower can have serious consequences. Here's how to save your stash—and your bud.

If you indulge frequently, chances are it’ll happen at least once. Maybe you take a weeklong vacation during the humid heights of summer; maybe you misplace your stash in the bathroom cabinet next to the shower; maybe you just buy a bad batch to begin with. In any case, you open your container, ready to partake, and look down at the sad state of your stash. It’s moldy.
Moldy flower is more than just a huge, icky disappointment—it could be dangerous. Learn how to spot mold, why mold happens, and the proper storage steps you can take to prevent it from happening again.
How Can You Spot Moldy Flower?
The easiest way to spot mold is to look for anything out of the ordinary. Particularly, look for gray-white powdery patches on the bud, discolored stems, or—most obviously—slime.
So, how do you differentiate mold on weed from, say, a particularly white dusting of trichomes (those hairy filaments carrying terpene goodness)? You wouldn’t want to throw away a perfectly good bud out of confusion. Trichomes have a shimmery, glittery white appearance, whereas mold has a matte, flat, powdery appearance akin to flour. Do an up-close inspection, and follow this golden rule: if there’s shine, it’s fine—but powdery and white? That’s not alright.
Lastly, get your nose involved. Your olfactory senses are a fantastic barometer for quality. If your flower smells musty or mushroomy, it’s probably moldy.
Why Does Mold Happen?
Mold happens when buds are exposed to high relative humidity (high water vapor density) and moisture. Mold spores thrive in damp, humid environments. They attach to a substrate (in this case, your stash) and extract its carbon to grow and multiply, but to do this, they need a fresh supply of water in the substrate. That supply might be the ambient water vapor in a bathroom, the condensation in a clear jar next to a sunny window, or just a humid climate. An improper cure in a high-humidity environment can also result in mold.
Smoking Moldy Flower: Harmful or Just Gross?
What happens if you smoke moldy flower? No surprises here: it can cause serious harm.
On one end of the spectrum, symptoms of smoking moldy flower could be less severe (but still undesirable). You might experience nausea or vomiting.
On the other end, there’s a whole world of bad. In a study at UC Davis, certain mold samples they tested turned up with strains like Cryptococcus, Aspergillus, and Mucor that can cause fatal infections. People with compromised immune systems or mold allergies need to be particularly careful.
But surely the fire from your lighter will snuff out any malicious actors lingering in the bud—right? Unfortunately, that isn’t the case. Some of the worst mold strains feature resilient, heat-resistant spores.
What to Do if You Spot Mold on Your Flower
Given the harmful effects of smoking moldy flower, your best option is to play it safe. Don’t be a walking test subject for mold side effects. Just toss it out.
You might be tempted to salvage some cannabis by “scraping off the outside.” Unfortunately, this isn’t a hard cheese, and humidity for flower doesn’t work that way. Flower has a loose structure replete with nooks and crannies, and mold has no trouble penetrating the base of a bud.
How to Prevent Mold on My Flower
We’ve covered what happens when you smoke moldy flower. We’ve covered what to do if you spot some of that telltale gray-white powder stinking up the joint (literally). But what happens afterward, when you’re staring down at the trash can, mourning the loss of an unsmoked stash?
You rebuild. And this time, you store your stash properly to ensure that mold never happens again. First, make sure your flower is fully cured: post-cured bud is significantly less likely to develop mold.
Then, find a tightly sealed container. This could be a dedicated humidor, a CVault, or simply a mason jar. Next, keep it out of the sunlight and ideally away from moist areas of the home, like the bathroom or kitchen.
Finally, pop a Boveda in your stash container. Boveda’s food-safe saltwater solution regulates humidity by drawing in moisture when the environment is too damp and releasing moisture when conditions are too dry.
If you live in an area defined by massive swings in humidity, Boveda minimizes these fluctuations inside your airtight storage container to serve you a fresh, potent, and safe bud every time.
Never Too Moist, Never Too Dry
But what if you have just the opposite problem? Instead of mold, you’re faced with a harsh, dry, brittle stash—well, Vivi’s precise humidity control can help with that too. Follow the link to learn more about how to rehydrate dry flower.
To summarize, moldy weed has no place in your rolling papers. It can be dangerous, even when smoked at high temperatures. Your best course of action is to throw out the affected stash and start fresh with new bud and a new airtight storage container.